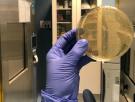
Del agar al hangar: cinco visitas que han enriquecido mi 2018

Javi Polinario
Periodista y comunicador digital
Periodista especializado en redes sociales y contenidos digitales. Socio fundador y director de la agencia de comunicación y 'marketing' Nexalios Comunica. Formador en redes sociales, redacción 'online' y comunicación de la ciencia. Ha publicado 'Cómo divulgar ciencia a través de las redes sociales'. “Me encanta descubrir nuevas historias y escribir sobre ellas. Últimamente lo hago sobre todo de ciencia y tecnología.”







La tecnología resucita a Dalí
13/05/2019

Tras la verdad del wolframio
12/11/2018

Crecer con dolor
23/10/2018

Mirar lo que no se ve
10/09/2018

Entre los bastidores del museo
04/08/2018

Jóvenes que quieren llegar muy arriba
25/06/2018

El valor que no se ve
14/06/2018






Que el ritmo no pare
06/04/2018
- 1
- 2
Tendencias
Newsletter









